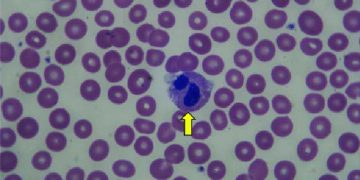
Yalancı Pelger-Huet Anomalisi Nedir?

Yalancı Kolinesteraz, karaciğerde sentezlenen, plazmada bulunan, asetilkolini asetik asit ve koline hidrolize eden enzime denir. Pseudocholinesterase
Read moreDetailsVetRehberi, Veteriner Hekimlik mesleği, hayvan sağlığı, hayvan hastalıkları, hayvan beslenmesi, hayvan ırkları, ebooks, sözlük, veteriner ilaçlar, yaban hayatı hakkında içerik yayınlayan ve soru-cevap ile hayvanlarınızın sorunlarına cevap veren bilgi platformudur.